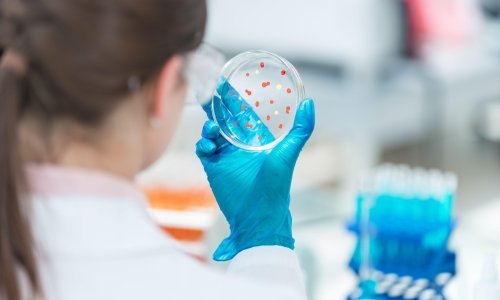

U protekla 24 sata zabilježeno je 255 novih slučajeva pa je broj trenutno oboljelih (aktivnih slučajeva) u Hrvatskoj danas 1.689. Među njima je 127 pacijenata na bolničkom liječenju, od toga je na respiratoru 13 pacijenata. U protekla 24 sata testirano je 2397 osoba, izvijestio je Nacionalni stožer
23.01 Ravnatelj OB Zadar, Željko Čulina, potvrdio je Zadarski kako je na Covid-19 pozitivan i jedan kirurg iz zadarske bolnice. On se netom vratio s godišnjeg odmora. Nitko od kolega, s kojima je bio u kontaktu, nije pozitivan. 'Nema razloga za paniku, testirali smo sve kontakte i svi su negativni. U izolaciju smo, po preporuci epidemiologa, stavili četiri kirurga. Svi pacijenti ce biti obrađeni i operirani', kazao je Čulina.
20.55 Francuska u četvrtak bilježi tisuću više novozaraženih koronavirusom nego dan ranije, a i druge europske države koje su u ožujku i travnju bile snažno pogođene pandemijom ponovno imaju rast broja novooboljelih, objavljuju njihove vlasti u četvrtak >>>Cijeli članak<<<
20.31 Mislimo da su mjere dobre. Nažalost ne drže ih se svi, komentirao je ravnatelj Hrvatskog zavoda za javno zdravstvo Krunoslav Capak rekordan broj novozaraženih koronavirusom u Hrvatskoj >>>Cijeli članak<<<
19.19 Hrvatska je danas, s 255 novooboljelih, ponovno srušila rekord broja novozaraženih od koronavirusa u jednom danu. Ministar zdravstva Vili Beroš gostovao je u RTL-u Danas i komentirao stavljanje na crvene liste >>>Cijeli članak<<<
18.41 Sloveniija je stavila Hrvatsku na crvenu listu. Vlada u Ljubljani je na popodnevnoj sjednici odlučila kako će svi slovenski građani koji dolaze iz Hrvatske morati u 14-dnevnu samoizolaciju, a zadnji rok za povratak u zemlju bez samoizolacije je ponedjeljak. Odluka vrijedi za cijelu Hrvatsku, nema županija koje su izuzete. Iznimka su jedino slovenski vlasnici plovila i nekretnina u našoj zemlji koji će imati 48 sati dulji rok da odrade sve što je potrebno za povratak u Sloveniju.
18.14 Podaci govore da moramo maknuti Hrvatsku, Austriju te Trinidad i Tobago s naše liste zemlja sigurnih za putovanje. Ako stignete u Ujedinjeno Kraljevstvo iz tih zemalja nakon četiri sata ujutro u subotu morat ćete u samoizolaciju od 14 dana, napisao je na Twitteru britanski ministar prometa Grant Shapps. >>>Cijeli članak<<<
18.06 Koronavirus je od početka pandemije u Crnoj Gori odnio živote 81 stanovnika te male države s nešto više od 600 tisuća stanovnika, dok je u četvrtak prema službenim podacima najmanje još 13 pacijenata u životnoj opasanosti >>>Cijeli članak<<<
16.52 Masovno testiranje prvog ruskog potencijalnog cjepiva protiv covida-19, koje je dobilo odobrenje ruskih vlasti, obuhvatit će više od 40.000 ljudi i nadzirat će ga strano znanstveno tijelo, kazali su u četvrtak dužnosnici koji razvijaju projekt >>>Cijeli članak<<<
15.50 Gotovo trideset posto stanovništva indijske prijestolnica New Delhija vjerojatno je zaraženo koronavirusom, proizlazi iz serološkog testiranja 150 tisuća stanovnika New Delhija, koje je provela lokalna vlast, što pokazuje da je broj zaraženih puno veći od službene brojke. U sklopu istraživanja provedeni su testovi na antitijela stanovnika New Delhija tijekom prvog tjedna kolovoza, kazao je ministar zdravstva New Delhija Satyendra Jain na novinskoj konferenciji u četvrtak. "Ustanovili smo da 29,1 posto stanovnika New Delhija ima antitijela, što znači da su bili zaraženi te da su izliječeni", kazao je Jain. >>>Cijeli članak<<<
15.33 U Srbiji je od posljedica koronavirusa u posljednja 24 sata preminulo pet osoba, čime se ukupan broj povećao na 689, objavilo je tamošnje Ministarstvo zdravlja, a prenosi N1. U istom je periodu zabilježena 161 novozaražena osoba, pa je od početka pandemije potvrđeno ukupno 30.209 zaraženih osoba. Na respiratorima su 52 pacijenta, a postotak smrtnosti je 2,28 posto. Do 15 sati 20. kolovoza u Srbiji je testirana ukupno 842.441 osoba.
14.51 Slovenska vlada danas popodne će donijeti odluku o tome hoće li Hrvatsku staviti na crvenu listu, javlja 24ur. Stavljanje na crvenu listu znači da bi svi koji dolaze u Sloveniju iz Hrvatske morali u dvotjednu karantenu. >>> Cijeli tekst <<<
Najnoviji podaci po županijama:
- Virovitičko-podravska županija - 4 novozaražena
- Koprivničko-križevačka županija - 3 novozaražena
- Sisačko-moslavačka županija - 1 novozaraženi
- Istarska županija - 27 novozaraženih
- Primorsko-goranska županija - 9 novozaraženih
- Bjelovarsko-bilogorska županija - 2 novozaražena
- Osječko-baranjska županija - 5 novozaraženih
- Vukovarsko-srijemska županija - 13 novozaraženih
- Grad Zagreb - 44 novozaraženih
- Ličko-senjska županija - 2 novozaražena
- Zadarska županija - 9 novozaraženih
- Međimurska županija - 1 novozaraženi
- Brodsko-posavska županija - 11 novozaraženih
- Šibensko-kninska županija - 8 novozaraženih
- Zagrebačka županija - 7 novozaraženih
- Karlovačka županija - 6 novozaraženih
- Varaždinska županija - 4 novozaražena
- Splitsko-dalmatinska županija - 75 novozaraženih
- Dubrovačko-neretvanska županija - 8 novozaraženih
14.41 Istarska županija u četvrtak je zabilježila 27 novih slučajeva zaraze, što je veliki skok u odnosu na prošle dane. "Jedan je vezana uz pogon za obradu mesa, tu je 12 osoba. Šest osoba je vezano za dva vrtića, odnosno predškolski odgoj. Ljudi su bili u samoizolaciji i to su kontakti koji su bili pozitivni. Tri osobe su unijele virus na područje županije. To je situacija koja nije izvan kontrole", ističe načelnik županijskog Stožera civilne zaštite Dino Kozlevac. >>> Cijeli tekst <<<
14.00 U protekla 24 sata zabilježeno je 255 novih slučajeva pa je broj trenutno oboljelih (aktivnih slučajeva) u Hrvatskoj danas 1.689. Među njima je 127 pacijenata na bolničkom liječenju, od toga je na respiratoru 13 pacijenata. U protekla 24 sata testirano je 2397 osoba. Od 25. veljače 2020., kada je zabilježen prvi slučaj zaraze u Hrvatskoj, do danas je ukupno zabilježeno 7.329 osoba zaraženih novim koronavirusom, od čega 255 u protekla 24 sata. 5.472 osoba se oporavilo, a dosad je preminulo stotinu šezdeset i osam soba. Do danas je ukupno testirana 144.521 osoba, od toga 2397 u protekla 24 sata.
13.55 U Dubrovačko-neretvanskoj županiji u posljednja 24 sata zabilježeno je 8 novih slučajeva zaraze koronavirusom. Riječ je o muškoj i ženskoj osobi iz Zagreba koji trenutno borave u općini Slivno, po jedna muška osoba iz Konavala, Opuzena i Dubrovnika te jedna muška osoba iz Kule Norinske koja ima boravište u Dubrovniku.
13.50 U Bosni i Hercegovini u četvrtak je potvrđeno 338 novih slučajeva zaraze koronavirusom nakon testiranja više od 1800 uzoraka, podaci su zavoda za javno zdravstvo s različitih razina vlasti. >>> Cijeli tekst <<<
13.08 Prema izvješću Nastavnog zavoda za javno zdravstvo Splitsko-dalmatinske županije, od ukupno 538 obrađenih testova danas je 75 novooboljelih osoba pozitivno na COVID infekciju i to iz Splita 26, Podstrane 2, Sinja 6, Dugog Rata 4, Makarske 12, Kaštela 4, Starog Grada 1, Hvara 2, Solina 2, Vrlike 4, Šestanovca 1, Tučepi 3, Otoka 2, Imotskog 5 i Marine 1 osoba. Od 75 novooboljelih osoba s područja Splitsko-dalmatinske županije 10 osoba su kontakti prethodno oboljelih osoba dok se ostali novooboljeli epidemiološki obrađuju.
12.38 U posljednja 24 sata u Varaždinskoj županiji zabilježena su četiri nova slučaja zaraze koronavirusom. Radi se o tri bliska obiteljska kontakta prethodno zaraženih osoba, dvije osobe starije životne dobi i jedna srednje životne dobi, s blažim kliničkim slikama i liječe se kod kuće. Kod četvrte osobe radi se o ženi srednjih godina, koja se epidemiološki još obrađuje, za sada nepoznatog izvora zaraze, a koja se također zbog blaže kliničke slike liječi kod kuće. Tijekom jučerašnjeg dana jedna je osoba zbog srednje teške kliničke slike s kućnog liječenja prebačena u Opću bolnicu Varaždin na bolničko liječenje.
12.34 U Karlovačkoj županiji su testirane 94 osobe (od čega 14 u Ogulinu). U posljednja 24 sata od ukupno testiranih osoba njih 6 je pozitivno na covid-19, 4 žene i 2 muškarca i uglavnom se radi o mlađim osobama. Četiri osobe su kontakti već prije oboljelih osoba, 1 osoba se vratila s godišnjeg odmora na moru, a za jednu osobu za sada nije utvrđen izvor zaraze. Epidemiološka obrada je u tijeku. 2 osobe su s područja Karlovca, 1 osoba iz općine Draganić, 1 osoba iz općine Barilović, 1 osobe iz Ogulina te 1 osoba iz Lasinje.
12.22 Šibensko-kninska i Splitsko-dalmatinska županija stavljene su danas na njemačku crvenu listu kao rizično područje za zarazu koronavirusom. Odluku je donio Robert Koch institut (RKI), ustanova koja upravlja pandemijom koronavirusa u Njemačkoj. RKi svoju odluku obrazlaže porastom broja novozaraženih u tim županijama. Klasifikacija rizičnog područja znači da svi povratnici moraju obaviti testiranje na Covid-19, a do primitka rezultata ostati u samoizolaciji, piše Večernji list.
11.52 U Šibensko-kninskoj županiji je 8 novooboljelih, svi s područja Grada Šibenika.
11.48 Sedam novih slučajeva covida-19 u Zagrebačkoj županiji.
11.46 U Brodsko-posavskoj županiji u četvrtak je zabilježeno 11 novozaraženih koronavirusom, izvijestio je županijski Stožer Civilne zaštite.U toj županiji trenutno je 59 osoba pozitivnih na koronavirus. Od početka pandemije koronavirus je potvrđen kod ukupno 246 osoba koje imaju prebivalište u Brodsko-posavskoj županiji, a tri osobe su preminule.Trenutno su u samoizolaciji 292 osobe, s ciljem sprečavanja širenja zaraze koronavirusom.
11.36 U Međimurskoj županiji jedna je novooboljela osoba te je ukupno 25 aktivnih slučajeva zaraze koronavirusom, izvijestili su u četvrtak županijskog Stožera Civilne zaštite te napomenuli da je ta županija osigurala pola milijuna kuna za nabavku novog PCR uređaja.
11.30 Devet je novih slučajeva zaraze koronavirusom u Zadarskoj županiji, a kod novooboljelih je uglavnom riječ o obiteljskim kontaktima ranije oboljelih, izvijestio je županijski Stožer civilne zaštite.
11.26 U Sloveniji je u zadnja 24 sata sa 1168 provedenih testiranja potvrđeno 43 novih slučajeva zaraze koronavirusom, šest više nego prethodni dan, objavila je u četvrtak slovenska vlada.
11.18 Na području Ličko-senjske županije u posljednja 24 sata dvije su novooboljele osobe. Oboljele osobe su s područja Primorsko-goranske te Šibensko-kninske županije. Na području Ličko-senjske županije su u izolaciji. Ukupno je oboljelo 39 osoba od covida-19 s područja Ličko-senjske županije od čega je 8 aktivnih slučajeva, 30 osoba je izliječeno te jedna osoba preminula. Do danas je potvrđen virus kod dvoje stranih državljana koji borave na našem području. U protekla 24 sata testirano je 18 osoba. U samoizolaciji su 54 osobe.
11.03 U Gradu Zagrebu potvrđeno je 44 novozaraženih.
10.46 U Vukovarsko-srijemskoj županiji u posljednja 24 sata potvrđeno je 13 novih slučajeva zaraze koronavirusom, a jedna je osoba preminula, javio je županijski Stožer civilne.
10.19 U zadnja 24 sata za područje Osječko-baranjske obrađeno je ukupno 203 uzorka od kojih su pet bili pozitivni na koronavirus. Novooboljele osobe su iz Osijeka, Vuke, Đakova, Petrijevaca i Našica. Mjera samoizolacije određena je za 21 kontakt osobu novooboljelih, pa je sada u samoizolaciji ukupno 284 osoba.
10.10 Ministar vanjskih i europskih poslova Gordan Grlić Radman dao je izjavu prije sjednice Vlade i osvrnuo se na epidemiološku situaciju. Kazao je kako je u srijedu razgovarao s talijanskim i njemačkim ministrom vanjskih poslova vezano uz stavljanje Hrvatske na crvenu listu. 'Njemačka će ići parcijalno. Pretpostavljam, ta odluka tek treba biti donesena. Ja sam u razgovorima s ministrom dobio takvu informaciju', rekao je Grlić Radman. >>> Cijeli tekst <<<
9.37 Na području Bjelovarsko-bilogorske županije dva su nova slučaja zaraze koronavirusom, s tim da je jedna od dvije zaražene osobe testirana u našoj županiji, ali ima prebivalište izvan Bjelovarsko-bilogorske županije. Novooboljele osobe nisu kontakti ranije zaraženih COVIDOM-19 u našoj županiji.Trenutno je na području naše županije 9 aktivnih slučajeva zaraze koronavirusom. U samoizolaciji je u našoj županiji 106 osoba.
9.34 Iz Primorsko-goranske županije izvjestili su o devet novozaraženih osoba. Svi su mlađe životne dobi. Osmero njih su povratnici s godišnjeg odmora, uglavnom po Dalmaciji, a jedna je osoba došla iz Austrije.
9.22 Tijekom protekla 24 sata u Zavodu za javno zdravstvo Istarske županije ispitano je 320 uzoraka briseva (155 za administrativne potrebe) na COVID-19, od kojih je 27 pozitivno. U 18 slučajeva radi se o osobama iz mjera samoizolacije, bliski kontakti s pozitivnim osobama, a povezani su s ranije izvještavanim događajima (objekt za preradu i prodaju mesa, predškolske ustanove u Puli i Vrsaru). Kod 3 osobe radi se o uvezenim slučajevima (poslovni boravak u Republici Srbiji i boravak na području srednje Dalmacije). Za 6 osoba u tijeku je epidemiološka obrada. Izliječena je 1 osoba. Trenutno je 49 aktivnih COVID-19 pozitivnih osoba. U mjerama samoizolacije nalazi se 170 osoba.
9.02 U Sisačko-moslavačkoj županiji jedna je novooboljela osoba od zarazne bolesti COVID-19. Osoba je s područja grada Siska.
8.46 Na području Virovitičko-podravske županije četiri su novozaražene osobe virusom SARS-CoV-2. Tri su žene mlađe, a jedna srednje životne dobi. Sve imaju blage simptome i nalaze se na kućnom liječenju. Jedna od njih je zdravstvena radnica. Iz Stožera civilne zaštite Virovitičko-podravske županije podcrtavaju na odgovorno ponašanje i pridržavanje epidemioloških mjera kako bi se spriječilo širenje zaraze.
8.44 Stožer civilne zaštite Koprivničko-križevačke županije izvjestio je kako su pristigli nalazi 39 testiranih uzoraka na SARS-CoV-2 u posljednja 24 sata te su potvrđena 3 nova slučaja zaraze koronavirusom. Riječ je o mlađim osobama s koprivničkog i đurđevačkog područja, jedna osoba je kontakt zaražene osobe, a dvije osobe nisu povezane s trenutno aktivnim zaraženim slučajevima, već su razvile simptome bolesti nakon povratka s ljetovanja. U tijeku je daljnja epidemiološka obrada bliskih kontakata novo zaraženih osoba te se u narednom razdoblju očekuje povećanje broja zaraženih osoba.
7.02 Oštre poruke stižu iz Slovenije, glasnogovornik njihove vlade Jerko Kacin rekao je da će se Hrvatska od četvrtka i službeno naći na njihovoj crvenoj listi. Hrvatska je nesigurna i stanje je dramatično, poručuju Slovenci. >>> Cijeli tekst <<<
6.42 U srijedu je zabilježeno 219 novih slučajeva pa je broj trenutno oboljelih (aktivnih slučajeva) u Hrvatskoj 1.520. Među njima su 122 pacijenata na bolničkom liječenju, od toga je na respiratoru 11 pacijenata. Testirane su 1653 osobe.
Novo žarište izbilo je u Imotskom, javlja Hrvatski radio.
6.19 Hrvatska bi u četvrtak mogla biti uklonjena s popisa sigurnih koridora za putovanje Velike Britanije, nakon što su tamo potvrđeni prvi uvezeni slučajevi koronavirusa povezani s boravkom našoj zemlji, piše The Guardian. >>> Cijeli tekst <<<



















![[FOTO/VIDEO] Doznali smo boli li uzimanje brisa za koronu i što najviše muči ljude koji rade na drive-in testiranju. 'Nisu mi jasni oni koji žele baš sve obaviti iz automobila. Pa nismo mi McDonald's, već zdravstvena ustanova!'](/media/thumbnail/500x300/1295490.jpeg?cropId=0)